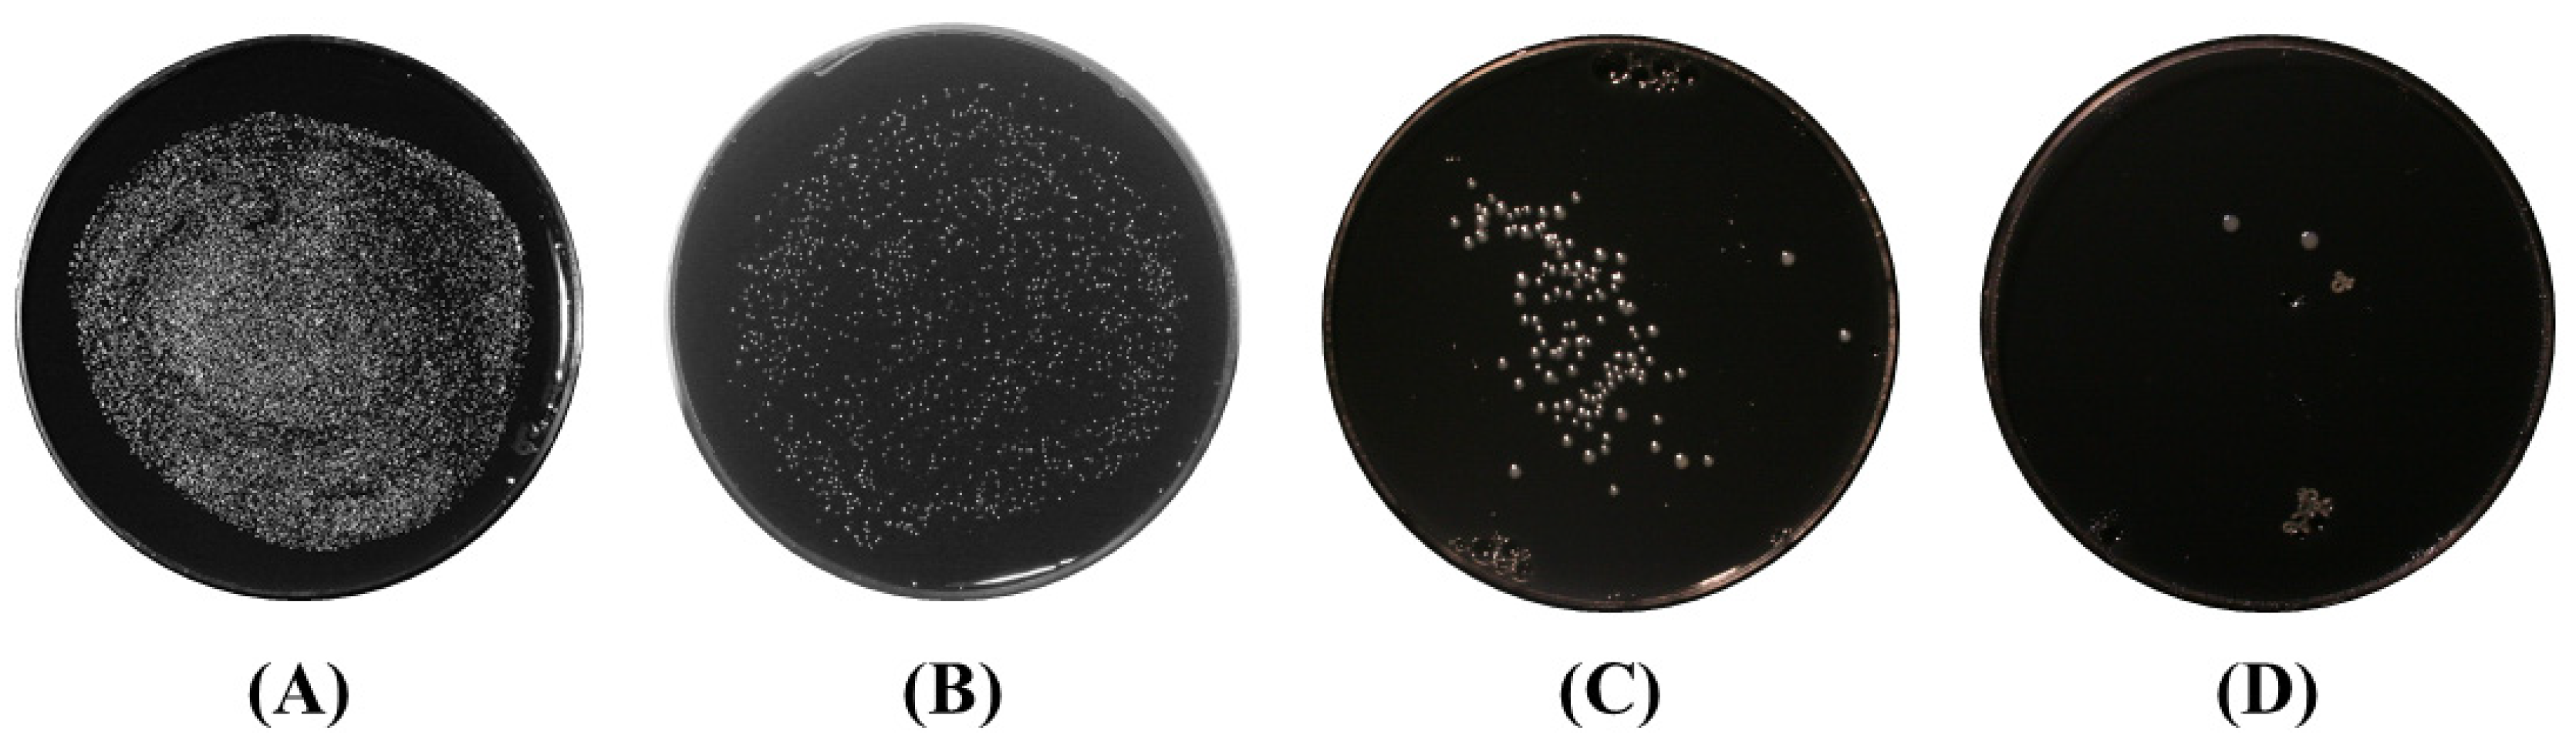
Applsci 12 04711 g006

Low Temperature Plasma Strategies for Xylella fastidiosa Inactivation
Abstract
:1. Introduction
2. Materials and Methods
2.1. Dielectric Barrier Discharge
2.2. Emission Spectroscopy
2.3. PAW Characterization
2.4. Xylella fastidiosa Growth Conditions and Plasma Treatments
2.4.1. Treatment of Agar Surface-Grown Bacteria
2.4.2. Treatment Cells with Plasma Activated Water (PAW)
3. Results
3.1. Plasma Current Voltage and Emission Spectroscopy
3.2. PAW Characterization
3.3. XfDD Growth Conditions and Plasma Treatments
Treatment of Agar Surface-Grown Bacteria
3.4. Inactivation of Suspension of X. fastidiosa by Plasma Activated Water
4. Discussion and Conclusions
Author Contributions
Funding
Institutional Review Board Statement
Informed Consent Statement
Conflicts of Interest
References
- Redak, R.A.; Purcell, A.H.; Lopes, J.R.S.; Blua, M.J.; Mizell, R.F.; Andersen, P.C. The Biology of Xylem Fluid-Feeding Insect Vectors of Xylella fastidiosa and Their Relation to Disease Epidemiology. Annu. Rev. Entomol. 2004, 49, 243–270. [Google Scholar] [CrossRef] [PubMed]
- Schaad, N.W.; Postnikova, E.; Lacy, G.; Fatmi, M.; Chang, C.-J. Xylella fastidiosa Subspecies: X. fastidiosa Subsp Piercei, Subsp. Nov., X. fastidiosa Subsp. Multiplex Subsp. Nov., and X. fastidiosa Subsp. Pauca Subsp. Nov. Syst. Appl. Microbiol. 2004, 27, 290–300. [Google Scholar] [CrossRef] [PubMed]
- Saponari, M.; Giampetruzzi, A.; Loconsole, G.; Boscia, D.; Saldarelli, P. Xylella Fastidiosa in Olive in Apulia: Where We Stand. Phytopathology 2019, 109, 175–186. [Google Scholar] [CrossRef] [PubMed] [Green Version]
- European Food Safety Authority (EFSA). Update of the Xylella spp. Host Plant Database—Systematic Literature Search up to 30 June 2019. EFSA J. 2020, 18, e06114. [Google Scholar] [CrossRef]
- Saponari, M.; Boscia, D.; Altamura, G.; Loconsole, G.; Zicca, S.; D’Attoma, G.; Morelli, M.; Palmisano, F.; Saponari, A.; Tavano, D.; et al. Isolation and Pathogenicity of Xylella fastidiosa Associated to the Olive Quick Decline Syndrome in Southern Italy. Sci. Rep. 2017, 7, 17723. [Google Scholar] [CrossRef]
- Marchi, G.; Rizzo, D.; Ranaldi, F.; Ghelardini, L.; Ricciolini, M.; Scarpelli, I.; Drosera, L.; Goti, E.; Capretti, P.; Surico, G. First Detection of Xylella fastidiosa Subsp. Multiplex DNA in Tuscany (Italy). Phytopathol. Mediterr. 2018, 57, 363–364. [Google Scholar]
- Soubeyrand, S.; de Jerphanion, P.; Martin, O.; Saussac, M.; Manceau, C.; Hendrikx, P.; Lannou, C. Inferring Pathogen Dynamics from Temporal Count Data: The Emergence of Xylella fastidiosa in France Is Probably Not Recent. New Phytol. 2018, 219, 824–836. [Google Scholar] [CrossRef] [Green Version]
- Olmo, D.; Nieto, A.; Borràs, D.; Montesinos, M.; Adrover, F.; Pascual, A.; Gost, P.A.; Quetglas, B.; Urbano, A.; de Dios García, J.; et al. Landscape Epidemiology of Xylella fastidiosa in the Balearic Islands. Agronomy 2021, 11, 473. [Google Scholar] [CrossRef]
- Xylella fastidiosa. Available online: https://www.mapa.gob.es/es/agricultura/temas/sanidad-vegetal/organismos-nocivos/xylella-fastidiosa/ (accessed on 1 April 2022).
- Delbianco, A.; Gibin, D.; Pasinato, L.; Morelli, M. Update of the Xylella spp. Host Plant Database—Systematic Literature Search up to 31 December 2020. EFSA J. 2021, 19, e06674. [Google Scholar] [CrossRef]
- First Report of Xylella fastidiosa in Israel 2019/121. Available online: https://gd.eppo.int/reporting/article-6551 (accessed on 1 April 2022).
- Kaushik, N.K.; Ghimire, B.; Li, Y.; Adhikari, M.; Veerana, M.; Kaushik, N.; Jha, N.; Adhikari, B.; Lee, S.-J.; Masur, K.; et al. Biological and Medical Applications of Plasma-Activated Media, Water and Solutions. Biol. Chem. 2018, 400, 39–62. [Google Scholar] [CrossRef]
- Martines, E. Special Issue “Plasma Technology for Biomedical Applications”. Appl. Sci. 2020, 10, 1524. [Google Scholar] [CrossRef] [Green Version]
- Choi, E.H.; Uhm, H.S.; Kaushik, N.K. Plasma Bioscience and Its Application to Medicine. AAPPS Bull. 2021, 31, 1–38. [Google Scholar] [CrossRef]
- Puač, N.; Gherardi, M.; Shiratani, M. Plasma Agriculture: A Rapidly Emerging Field. Plasma Process. Polym. 2018, 15, 1700174. [Google Scholar] [CrossRef]
- Ambrico, P.F.; Šimek, M.; Rotolo, C.; Morano, M.; Minafra, A.; Ambrico, M.; Pollastro, S.; Gerin, D.; Faretra, F.; De Miccolis Angelini, R.M. Surface Dielectric Barrier Discharge Plasma: A Suitable Measure against Fungal Plant Pathogens. Sci. Rep. 2020, 10, 1–17. [Google Scholar] [CrossRef] [PubMed] [Green Version]
- Misra, N.N.; Tiwari, B.K.; Raghavarao, K.S.M.S.; Cullen, P.J. Nonthermal Plasma Inactivation of Food-Borne Pathogens. Food Eng. Rev. 2011, 3, 159–170. [Google Scholar] [CrossRef] [Green Version]
- Hähnel, M.; Von Woedtke, T.; Weltmann, K.D. Influence of the Air Humidity on the Reduction of Bacillus Spores in a Defined Environment at Atmospheric Pressure Using a Dielectric Barrier Surface Discharge. Plasma Process. Polym. 2010, 7, 244–249. [Google Scholar] [CrossRef]
- Ambrico, P.F.; Šimek, M.; Morano, M.; De Miccolis Angelini, R.M.; Minafra, A.; Trotti, P.; Ambrico, M.; Prukner, V.; Faretra, F. Reduction of Microbial Contamination and Improvement of Germination of Sweet Basil (Ocimum basilicum L.) Seeds via Surface Dielectric Barrier Discharge. J. Phys. D. Appl. Phys. 2017, 50, 305401. [Google Scholar] [CrossRef]
- Guo, J.; Huang, K.; Wang, J. Bactericidal Effect of Various Non-Thermal Plasma Agents and the Influence of Experimental Conditions in Microbial Inactivation: A Review. Food Control 2015, 50, 482–490. [Google Scholar] [CrossRef]
- Keener, K.M.M.; Misra, N.N.N. Future of Cold Plasma in Food Processing; Elsevier Inc.: Amsterdam, The Netherlands, 2016; ISBN 9780128013656. [Google Scholar]
- Dobrynin, D.; Fridman, G.; Friedman, G.; Fridman, A. Physical and Biological Mechanisms of Direct Plasma Interaction with Living Tissue. New J. Phys. 2009, 11, 115020. [Google Scholar] [CrossRef]
- Wan, J.; Coventry, J.; Swiergon, P.; Sanguansri, P.; Versteeg, C. Advances in Innovative Processing Technologies for Microbial Inactivation and Enhancement of Food Safety—Pulsed Electric Field and Low-Temperature Plasma. Trends Food Sci. Technol. 2009, 20, 414–424. [Google Scholar] [CrossRef]
- Ehlbeck, J.; Schnabel, U.; Polak, M.; Winter, J.; von Woedtke, T.; Brandenburg, R.; von dem Hagen, T.; Weltmann, K.-D. Low Temperature Atmospheric Pressure Plasma Sources for Microbial Decontamination. J. Phys. D Appl. Phys. 2010, 44, 013002. [Google Scholar] [CrossRef] [Green Version]
- Kvam, E.; Davis, B.; Mondello, F.; Garner, A.L. Nonthermal Atmospheric Plasma Rapidly Disinfects Multidrug-Resistant Microbes by Inducing Cell Surface Damage. Antimicrob. Agents Chemother. 2012, 56, 2028–2036. [Google Scholar] [CrossRef] [PubMed] [Green Version]
- Scholtz, V.; Pazlarova, J.; Souskova, H.; Khun, J.; Julak, J. Nonthermal Plasma—A Tool for Decontamination and Disinfection. Biotechnol. Adv. 2015, 33, 1108–1119. [Google Scholar] [CrossRef]
- Imlay, J.A. The Molecular Mechanisms and Physiological Consequences of Oxidative Stress: Lessons from a Model Bacterium. Nat. Rev. Microbiol. 2013, 11, 443–454. [Google Scholar] [CrossRef] [PubMed] [Green Version]
- Joshi, S.G.; Cooper, M.; Yost, A.; Paff, M.; Ercan, U.K.; Fridman, G.; Friedman, G.; Fridman, A.; Brooks, A.D. Nonthermal Dielectric-Barrier Discharge Plasma-Induced Inactivation Involves Oxidative DNA Damage and Membrane Lipid Peroxidation in Escherichia coli. Antimicrob. Agents Chemother. 2011, 55, 1053–1062. [Google Scholar] [CrossRef] [PubMed] [Green Version]
- Fang, F.C. Antimicrobial Reactive Oxygen and Nitrogen Species: Concepts and Controversies. Nat. Rev. Microbiol. 2004, 2, 820–832. [Google Scholar] [CrossRef]
- Šimek, M.; Pekárek, S.; Prukner, V. Ozone Production Using a Power Modulated Surface Dielectric Barrier Discharge in Dry Synthetic Air. Plasma Chem. Plasma Process. 2012, 32, 743–754. [Google Scholar] [CrossRef]
- Mai-Prochnow, A.; Murphy, A.B.; McLean, K.M.; Kong, M.G.; Ostrikov, K. (Ken) Atmospheric Pressure Plasmas: Infection Control and Bacterial Responses. Int. J. Antimicrob. Agents 2014, 43, 508–517. [Google Scholar] [CrossRef]
- Doležalová, E.; Prukner, V.; Lukeš, P.; Šimek, M. Stress Response of Escherichia coli Induced by Surface Streamer Discharge in Humid Air. J. Phys. D Appl. Phys. 2016, 49, 075401. [Google Scholar] [CrossRef]
- Graves, D.B. The Emerging Role of Reactive Oxygen and Nitrogen Species in Redox Biology and Some Implications for Plasma Applications to Medicine and Biology. J. Phys. D Appl. Phys. 2012, 45, 263001–263042. [Google Scholar] [CrossRef]
- Pavlovich, M.J.; Clark, D.S.; Graves, D.B. Quantification of Air Plasma Chemistry for Surface Disinfection. Plasma Sources Sci. Technol. 2014, 23, 065036. [Google Scholar] [CrossRef]
- Jeong, J.; Kim, J.Y.; Yoon, J. The Role of Reactive Oxygen Species in the Electrochemical Inactivation of Microorganisms. Environ. Sci. Technol. 2006, 40, 6117–6122. [Google Scholar] [CrossRef]
- Frederickson Matika, D.E.; Loake, G.J. Redox Regulation in Plant Immune Function. Antioxid. Redox Signal. 2014, 21, 1373–1388. [Google Scholar] [CrossRef]
- Yu, H.; Perni, S.; Shi, J.J.; Wang, D.Z.; Kong, M.G.; Shama, G. Effects of Cell Surface Loading and Phase of Growth in Cold Atmospheric Gas Plasma Inactivation of Escherichia coli K12. J. Appl. Microbiol. 2006, 101, 1323–1330. [Google Scholar] [CrossRef] [PubMed]
- Sakiyama, Y.; Graves, D.B.; Chang, H.-W.; Shimizu, T.; Morfill, G.E. Plasma Chemistry Model of Surface Microdischarge in Humid Air and Dynamics of Reactive Neutral Species. J. Phys. D Appl. Phys. 2012, 45, 425201. [Google Scholar] [CrossRef]
- Machala, Z.; Tarabova, B.; Hensel, K.; Spetlikova, E.; Sikurova, L.; Lukes, P. Formation of ROS and RNS in Water Electro-Sprayed through Transient Spark Discharge in Air and Their Bactericidal Effects. Plasma Process. Polym. 2013, 10, 649–659. [Google Scholar] [CrossRef]
- Montie, T.C.; Kelly-Wintenberg, K.; Roth, J.R. An Overview of Research Using the One Atmosphere Uniform Glow Discharge Plasma (OAUGDP) for Sterilization of Surfaces and Materials. IEEE Trans. Plasma Sci. 2000, 28, 41–50. [Google Scholar] [CrossRef]
- Sykes, P. Introduction to Organic and Biochemistry. Biochem. Educ. 1973, 1, 59. [Google Scholar] [CrossRef]
- Mittler, R. ROS Are Good. Trends Plant Sci. 2017, 22, 11–19. [Google Scholar] [CrossRef] [Green Version]
- Mittler, R.; Vanderauwera, S.; Gollery, M.; Van Breusegem, F. Reactive Oxygen Gene Network of Plants. Trends Plant Sci. 2004, 9, 490–498. [Google Scholar] [CrossRef]
- Erpen, L.; Devi, H.S.; Grosser, J.W.; Dutt, M. Potential Use of the DREB/ERF, MYB, NAC and WRKY Transcription Factors to Improve Abiotic and Biotic Stress in Transgenic Plants. Plant Cell. Tissue Organ Cult. 2018, 132, 1–25. [Google Scholar] [CrossRef]
- Hoang, X.L.T.; Nhi, D.N.H.; Thu, N.B.A.; Thao, N.P.; Tran, L.-S.P. Transcription Factors and Their Roles in Signal Transduction in Plants under Abiotic Stresses. Curr. Genom. 2017, 18, 483–497. [Google Scholar] [CrossRef]
- Seo, E.; Choi, D. Functional Studies of Transcription Factors Involved in Plant Defenses in the Genomics Era. Brief. Funct. Genom. 2015, 14, 260–267. [Google Scholar] [CrossRef] [PubMed] [Green Version]
- Iranbakhsh, A.; Ghoranneviss, M.; Oraghi Ardebili, Z.; Oraghi Ardebili, N.; Hesami Tackallou, S.; Nikmaram, H. Non-Thermal Plasma Modified Growth and Physiology in Triticum Aestivum via Generated Signaling Molecules and UV Radiation. Biol. Plant. 2017, 61, 702–708. [Google Scholar] [CrossRef]
- Jain, D.; Khurana, J.P. Role of Pathogenesis-Related (PR) Proteins in Plant Defense Mechanism. In Molecular Aspects of Plant-Pathogen Interaction; Singh, A., Singh, I., Eds.; Springer: Singapore, 2018; pp. 265–281. [Google Scholar] [CrossRef]
- Noctor, G.; Lelarge-Trouverie, C.; Mhamdi, A. The Metabolomics of Oxidative Stress. Phytochemistry 2015, 112, 33–53. [Google Scholar] [CrossRef] [PubMed]
- Moon, U.R.; Mitra, A. A Mechanistic Insight into Hydrogen Peroxide-Mediated Elicitation of Bioactive Xanthones in Hoppea Fastigiata Shoot Cultures. Planta 2016, 244, 259–274. [Google Scholar] [CrossRef] [PubMed]
- Filatova, I.; Lyushkevich, V.; Goncharik, S.; Zhukovsky, A.; Krupenko, N.; Kalatskaja, J. The Effect of Low-Pressure Plasma Treatment of Seeds on the Plant Resistance to Pathogens and Crop Yields. J. Phys. D Appl. Phys. 2020, 53, 244001. [Google Scholar] [CrossRef]
- Kamgang-Youbi, G.; Herry, J.M.; Brisset, J.L.; Bellon-Fontaine, M.N.; Doubla, A.; Naïtali, M. Impact on Disinfection Efficiency of Cell Load and of Planktonic/Adherent/ Detached State: Case of Hafnia Alvei Inactivation by Plasma Activated Water. Appl. Microbiol. Biotechnol. 2008, 81, 449–457. [Google Scholar] [CrossRef] [Green Version]
- Hoeben, W.F.L.M.; van Ooij, P.P.; Schram, D.C.; Huiskamp, T.; Pemen, A.J.M.; Lukeš, P. On the Possibilities of Straightforward Characterization of Plasma Activated Water. Plasma Chem. Plasma Process. 2019, 39, 597–626. [Google Scholar] [CrossRef] [Green Version]
- Sergeichev, K.F.; Lukina, N.A.; Sarimov, R.M.; Smirnov, I.G.; Simakin, A.V.; Dorokhov, A.S.; Gudkov, S.V. Physicochemical Properties of Pure Water Treated by Pure Argon Plasma Jet Generated by Microwave Discharge in Opened Atmosphere. Front. Phys. 2021, 8, 596. [Google Scholar] [CrossRef]
- Zhou, R.; Zhou, R.; Prasad, K.; Fang, Z.; Speight, R.; Bazaka, K.; Ostrikov, K. Cold Atmospheric Plasma Activated Water as a Prospective Disinfectant: The Crucial Role of Peroxynitrite. Green Chem. 2018, 20, 5276–5284. [Google Scholar] [CrossRef]
- Guo, J.; Huang, K.; Wang, X.; Lyu, C.; Yang, N.; Li, Y.; Wang, J. Inactivation of Yeast on Grapes by Plasma-Activated Water and Its Effects on Quality Attributes. J. Food Prot. 2017, 80, 225–230. [Google Scholar] [CrossRef]
- Guo, J.; Wang, J.; Xie, H.; Jiang, J.; Li, C.; Li, W.; Li, L.; Liu, X.; Lin, F. Inactivation Effects of Plasma-Activated Water on Fusarium graminearum. Food Control 2022, 134, 108683. [Google Scholar] [CrossRef]
- Perez, S.M.; Biondi, E.; Laurita, R.; Proto, M.; Sarti, F.; Gherardi, M.; Bertaccini, A.; Colombo, V. Plasma Activated Water as Resistance Inducer against Bacterial Leaf Spot of Tomato. PLoS ONE 2019, 14, e0217788. [Google Scholar] [CrossRef]
- Adhikari, B.; Adhikari, M.; Ghimire, B.; Park, G.; Choi, E.H. Cold Atmospheric Plasma-Activated Water Irrigation Induces Defense Hormone and Gene Expression in Tomato Seedlings. Sci. Rep. 2019, 9, 16080. [Google Scholar] [CrossRef] [PubMed] [Green Version]
- Danilejko, Y.K.; Belov, S.V.; Egorov, A.B.; Lukanin, V.I.; Sidorov, V.A.; Apasheva, L.M.; Dushkov, V.Y.; Budnik, M.I.; Belyakov, A.M.; Kulik, K.N.; et al. Increase of Productivity and Neutralization of Pathological Processes in Plants of Grain and Fruit Crops with the Help of Aqueous Solutions Activated by Plasma of High-Frequency Glow Discharge. Plants 2021, 10, 2161. [Google Scholar] [CrossRef]
- ten Bosch, L.; Köhler, R.; Ortmann, R.; Wieneke, S.; Viöl, W. Insecticidal Effects of Plasma Treated Water. Int. J. Environ. Res. Public Health 2017, 14, 1460. [Google Scholar] [CrossRef] [Green Version]
- Zhang, Q.; Ma, R.; Tian, Y.; Su, B.; Wang, K.; Yu, S.; Zhang, J.; Fang, J. Sterilization Efficiency of a Novel Electrochemical Disinfectant against Staphylococcus Aureus. Environ. Sci. Technol. 2016, 50, 3184–3192. [Google Scholar] [CrossRef]
- Tarabová, B.; Lukeš, P.; Hammer, M.U.; Jablonowski, H.; Von Woedtke, T.; Reuter, S.; Machala, Z. Fluorescence Measurements of Peroxynitrite/Peroxynitrous Acid in Cold Air Plasma Treated Aqueous Solutions. Phys. Chem. Chem. Phys. 2019, 21, 8883–8896. [Google Scholar] [CrossRef]
- Aboubakr, H.A.; Gangal, U.; Youssef, M.M.; Goyal, S.M.; Bruggeman, P.J. Inactivation of Virus in Solution by Cold Atmospheric Pressure Plasma: Identification of Chemical Inactivation Pathways. J. Phys. D Appl. Phys. 2016, 49, 204001. [Google Scholar] [CrossRef]
- Pavlovich, M.J.; Chang, H.W.; Sakiyama, Y.; Clark, D.S.; Graves, D.B. Ozone Correlates with Antibacterial Effects from Indirect Air Dielectric Barrier Discharge Treatment of Water. J. Phys. D Appl. Phys. 2013, 46, 015202. [Google Scholar] [CrossRef]
- Fang, J.; Ma, R.; Wang, K.; Tian, Y.; Wang, G.; Zhang, J. Non-Thermal Plasma-Activated Water Inactivation of Food-Borne Pathogen on Fresh Produce. J. Hazard. Mater. 2015, 300, 643–651. [Google Scholar] [CrossRef]
- Mai-Prochnow, A.; Zhou, R.; Zhang, T.; Ostrikov, K.; Mugunthan, S.; Rice, S.A.; Cullen, P.J. Interactions of Plasma-Activated Water with Biofilms: Inactivation, Dispersal Effects and Mechanisms of Action. NPJ Biofilms Microbiomes 2021, 7, 1–12. [Google Scholar] [CrossRef] [PubMed]
- Chen, T.-P.; Su, T.-L.; Liang, J. Plasma-Activated Solutions for Bacteria and Biofilm Inactivation. Curr. Bioact. Compd. 2016, 13, 59–65. [Google Scholar] [CrossRef]
- Zhou, R.; Zhou, R.; Wang, P.; Luan, B.; Zhang, X.; Fang, Z.; Xian, Y.; Lu, X.; Ostrikov, K.K.; Bazaka, K. Microplasma Bubbles: Reactive Vehicles for Biofilm Dispersal. ACS Appl. Mater. Interfaces 2019, 11, 20660–20669. [Google Scholar] [CrossRef]
- Jiao, Y.; Tay, F.R.; Niu, L.; Chen, J. Advancing Antimicrobial Strategies for Managing Oral Biofilm Infections. Int. J. Oral Sci. 2019, 11, 28. [Google Scholar] [CrossRef] [Green Version]
- Cherny, K.E.; Sauer, K. Untethering and Degradation of the Polysaccharide Matrix Are Essential Steps in the Dispersion Response of Pseudomonas Aeruginosa Biofilms. J. Bacteriol. 2020, 202, e00575-19. [Google Scholar] [CrossRef]
- Glazebrook, J. Contrasting Mechanisms of Defense Against Biotrophic and Necrotrophic Pathogens. Annu. Rev. Phytopathol. 2005, 43, 205–227. [Google Scholar] [CrossRef]
- Grinberg, M.A.; Gudkov, S.V.; Balalaeva, I.V.; Gromova, E.; Sinitsyna, Y.; Sukhov, V.; Vodeneev, V. Effect of Chronic β-Radiation on Long-Distance Electrical Signals in Wheat and Their Role in Adaptation to Heat Stress. Environ. Exp. Bot. 2021, 184, 104378. [Google Scholar] [CrossRef]
- Voráč, J.; Synek, P.; Procházka, V.; Hoder, T. State-by-State Emission Spectra Fitting for Non-Equilibrium Plasmas: OH Spectra of Surface Barrier Discharge at Argon/Water Interface. J. Phys. D Appl. Phys. 2017, 50, 294002. [Google Scholar] [CrossRef]
- Voráč, J.; Synek, P.; Potočňáková, L.; Hnilica, J.; Kudrle, V. Batch Processing of Overlapping Molecular Spectra as a Tool for Spatio-Temporal Diagnostics of Power Modulated Microwave Plasma Jet. Plasma Sources Sci. Technol. 2017, 26, 025010. [Google Scholar] [CrossRef]
- Voráč, J.; Kusýn, L.; Synek, P. Deducing Rotational Quantum-State Distributions from Overlapping Molecular Spectra. Rev. Sci. Instrum. 2019, 90, 123102. [Google Scholar] [CrossRef] [PubMed]
- Giampetruzzi, A.; Saponari, M.; Loconsole, G.; Boscia, D.; Savino, V.N.; Almeida, R.P.P.; Zicca, S.; Landa, B.B.; Chacón-Diaz, C.; Saldarelli, P. Genome-Wide Analysis Provides Evidence on the Genetic Relatedness of the Emergent Xylella fastidiosa Genotype in Italy to Isolates from Central America. Phytopathology 2017, 107, 816–827. [Google Scholar] [CrossRef] [PubMed] [Green Version]
- Goldman, E.; Green, L.H. (Eds.) Practical Handbook of Microbiology, Second Edition; CRC Press, Taylor and Francis Group: Boca Raton, FL, USA, 2008. [Google Scholar]
- Breed, R.S.; Dotterrer, W.D. The Number of Colonies Allowable On Satisfactory Agar Plates. J. Bacteriol. 1916, 1, 321–331. [Google Scholar] [CrossRef] [PubMed] [Green Version]
- Dilecce, G.; Ambrico, P.F.; De Benedictis, S. New N2(C3Πu, v) Collision Quenching and Vibrational Relaxation Rate Constants: 2. PG Emission Diagnostics of High-Pressure Discharges. Plasma Sources Sci. Technol. 2007, 16, S45–S51. [Google Scholar] [CrossRef]
- Dilecce, G. Optical Spectroscopy Diagnostics of Discharges at Atmospheric Pressure. Plasma Sources Sci. Technol. 2014, 23, 015011. [Google Scholar] [CrossRef]
- Fernández, R.O.; Pizarro, R.A. Lethal Effect Induced in Pseudomonas Aeruginosa Exposed to Ultraviolet-A Radiation. Photochem. Photobiol. 1996, 64, 334–339. [Google Scholar] [CrossRef]
- Kvam, E.; Benner, K. Mechanistic Insights into UV-A Mediated Bacterial Disinfection via Endogenous Photosensitizers. J. Photochem. Photobiol. B Biol. 2020, 209, 111899. [Google Scholar] [CrossRef]
- Casadesús, J.; Low, D. Epigenetic Gene Regulation in the Bacterial World. Microbiol. Mol. Biol. Rev. 2006, 70, 830–856. [Google Scholar] [CrossRef] [Green Version]
- Cortese, E.; Settimi, A.G.; Pettenuzzo, S.; Cappellin, L.; Galenda, A.; Famengo, A.; Dabalà, M.; Antoni, V.; Navazio, L. Plasma-Activated Water Triggers Rapid and Sustained Cytosolic Ca2+ Elevations in Arabidopsis Thaliana. Plants 2021, 10, 2516. [Google Scholar] [CrossRef]
- Soni, A.; Choi, J.; Brightwell, G. Plasma-Activated Water (PAW) as a Disinfection Technology for Bacterial Inactivation with a Focus on Fruit and Vegetables. Foods 2021, 10, 166. [Google Scholar] [CrossRef] [PubMed]

| Time | N of Replicas | 11 Days CFU mL−1 | 13 Days CFU mL−1 | |
|---|---|---|---|---|
| 105 | untreated | 3 | 3.81 × 108 ± 3.7 × 106 | 9.79 × 108 ± 8.7 × 106 |
| 104 | 3 | 4.17 × 105 ± 2.7 × 105 | 2.17 × 107 ± 3.8 × 105 | |
| 103 | 3 | 0.00 | 1.92 × 105 ± 3.8 × 104 | |
| 105 | T0 | 3 | 0.00 | 0.00 |
| 104 | 3 | 0.00 | 0.00 | |
| 103 | 3 | 0.00 | 0.00 | |
| 105 | T5 | 3 | 0.00 | 0.00 |
| 104 | 3 | 0.00 | 0.00 | |
| 103 | 3 | 0.00 | 0.00 |
| Treatment Frequency | CSUSPENSION (CFU mL−1) | C11 11 DAYS | LOG GROWTH | C13 13 DAYS | LOG GROWTH | C15 15 DAYS | LOG GROWTH | C20 20 DAYS | LOG GROWTH |
|---|---|---|---|---|---|---|---|---|---|
| 105 | 1.1 × 109 ± 3.8 × 106 | 9 | 1.9 × 109 ± 8.7 × 106 | 9.3 | NC | NC | |||
| NT | 104 | 1.2 × 106 ± 3.8 × 105 | 6.1 | 6.5 × 107 ± 9.5 × 105 | 7.8 | 7.5 × 108 ± 1.3 × 106 | 8.9 | ||
| 103 | 0.0 | 6.0 × 105 ± 8.7 × 104 | 5.8 | 2.9 × 108 ± 6.3 × 104 | 8.5 | ||||
| TRIAL | 105 | 3.3 × 106 ± 1.4 × 106 | 6.5 | 4.2 × 106 ± 1.4 × 106 | 6.6 | ||||
| (A) | 104 | 1.3 × 104 ± 0.7 × 104 | 4.1 | 1.7 × 105 ± 1.4 × 105 | 5.2 | ||||
| 1/DAY | 103 | 0.0 | 0 | 0.0 | 0.0 | ||||
| TRIAL | 105 | 3.4 × 107 ± 6.3 × 106 | 7.5 | 1.6 × 108 ± 5.2 × 106 | 8.2 | ||||
| (B) | 104 | 3.3 × 105 ± 1.4 × 105 | 5.5 | 1.7 × 106 ± 1.4 × 105 | 6.2 | ||||
| 1/WEEK | 103 | 0.0 | 0.0 | 1.0 × 105 ± 5 × 104 | 5 |
Publisher’s Note: MDPI stays neutral with regard to jurisdictional claims in published maps and institutional affiliations. |
© 2022 by the authors. Licensee MDPI, Basel, Switzerland. This article is an open access article distributed under the terms and conditions of the Creative Commons Attribution (CC BY) license (https://creativecommons.org/licenses/by/4.0/).
Share and Cite
Ambrico, P.F.; Zicca, S.; Ambrico, M.; Rotondo, P.R.; De Stradis, A.; Dilecce, G.; Saponari, M.; Boscia, D.; Saldarelli, P. Low Temperature Plasma Strategies for Xylella fastidiosa Inactivation. Appl. Sci. 2022, 12, 4711. https://doi.org/10.3390/app12094711
Ambrico PF, Zicca S, Ambrico M, Rotondo PR, De Stradis A, Dilecce G, Saponari M, Boscia D, Saldarelli P. Low Temperature Plasma Strategies for Xylella fastidiosa Inactivation. Applied Sciences. 2022; 12(9):4711. https://doi.org/10.3390/app12094711
Chicago/Turabian StyleAmbrico, Paolo Francesco, Stefania Zicca, Marianna Ambrico, Palma Rosa Rotondo, Angelo De Stradis, Giorgio Dilecce, Maria Saponari, Donato Boscia, and Pasquale Saldarelli. 2022. "Low Temperature Plasma Strategies for Xylella fastidiosa Inactivation" Applied Sciences 12, no. 9: 4711. https://doi.org/10.3390/app12094711






